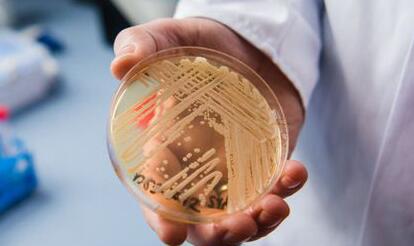
死亡率高达50%的病毒,中国有多少人感染超级真菌

“神秘而致命”的真菌全球扩散、死亡率超50%、中国已有18例感染?今日,“超级真菌在美国多地爆发”上了微博热搜,网友纷纷表示“太可怕了”。“超级真菌”究竟是什么,我们日常又该注意哪些问题呢?
“超级真菌”有多厉害?
据美国《纽约时报》报道,当地医院在为患者做手术时发现其感染了一种“神秘而致命”的真菌,医院迅速将其隔离在重症监护室。
可怕的是,即使在该患者死亡后,这种致命的真菌还顽强地存活下来,并入侵了医院大片区域,院方为此对墙壁、病床、门、水槽、电话都进行了特殊消毒,甚至拆除了部分天花板和地板。

目前,这种名为耳念珠菌的多重耐药真菌在美国已造成超500人感染,并在全球多地扩散。美媒称,目前专家坦言对其治疗束手无策。美国疾病控制与预防中心(CDC)专家形容,耳念珠菌犹如来去无踪的怪物,“它突然冒起,如今已遍布各地”。
事实上,耳念珠菌导致的病例并非首次出现:
英国一医院2015年底曾接收一名感染耳念珠菌的病人,造成至少72人受感染,医院经过三个多月仍未能完全消灭残留真菌。
西班牙一医院曾在372人身上发现耳念珠菌,其中85人出现血液感染,41%在30天内死亡。

截至2017年,全球已有24个国家出现耳念珠菌的爆发性流行,包括日本、美国、英国、西班牙、印度等国。
中国最早于2018年在北京大学人民医院发现首例耳念珠菌临床感染病例,此后陆续在京确诊2例,在沈阳确诊15例,截至目前,中国已确认18例“超级真菌”临床感染病例。
“耳念珠菌”从哪里来?
耳念珠菌,英文学名是Candida auris,由于第一次是在患者耳朵里分离出来,属于孢子形状如佛珠一样的念珠菌属,所以取名为耳念珠菌。

培养皿中的耳念珠菌菌株。
耳念珠菌的来源目前还不明确,是环境真菌还是人体共生菌,也不清楚。研究人员普遍认为,这是新近进化出来的、快速适应人体宿主环境能力的新物种,而抗药菌的出现,与人类滥用抗生素有关。

《纽约时报》报道,超过90%的耳念珠菌感染病例对至少一种主要的抗真菌药物耐受,30%对两种及两种以上的药物耐受。
另外,耳念珠菌能够在干燥和潮湿的表面、床上用品、地板、水槽、空气、床上、 皮肤、鼻腔和病人的内部组织等不同环境长时间存活,一旦医院等机构出现耳念珠菌,就很难杜绝其扩散。
面对“超级真菌”不必恐慌
不过,面对这种“致命的真菌”,我们也不需要过度恐慌。
中科院微生物研究所真菌学国家重点实验室研究员黄广华解释说,真菌感染主要发生医院内,集中在免疫力低下的人群,如ICU病房。美国的大规模流行也都是在院内发生的。耳念珠菌对健康人不会造成太大的影响。
实际上,真菌感染在我们日常生活中并不罕见,人们出汗浸渍在皮肤上,空气中的尘埃也会随着汗液黏附在皮肤上,这样很容易招致皮肤真菌感染。
致病的原因真菌喜欢温暖潮湿,浅部真菌最适宜的温度是22℃-28℃。当人体皮肤上有适合真菌生长繁殖的条件时,就容易发生癣病。
根据感染部位的不同,真菌感染可以分为浅部感染和深部感染。皮肤真菌感染中最常见的是皮肤念珠菌病,此外手足癣、股癣、甲癣等癣类也常发生。

虽然真菌感染具有传染性,但只要坚持良好的生活习惯,是可以预防的。
要建立良好的卫生习惯,勤换勤洗衣、袜以及生活用品。
要积极治疗局部的真菌病,以免交叉感染。治疗癣病要彻底,不能认为不痒了就停止用药,应由医生确定治疗时间。
要保持感染部位清洁、干燥有助于抑制真菌繁殖,促进皮肤愈合。
经常食用新鲜西红柿,其中的番茄素对于多种细菌和真菌有抑制作用。